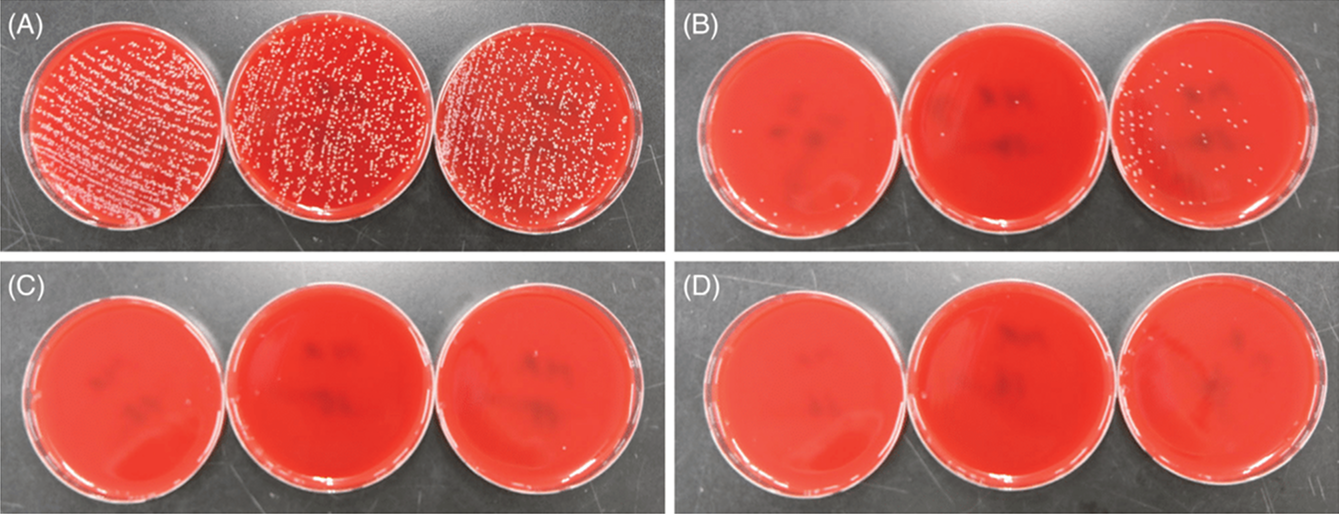
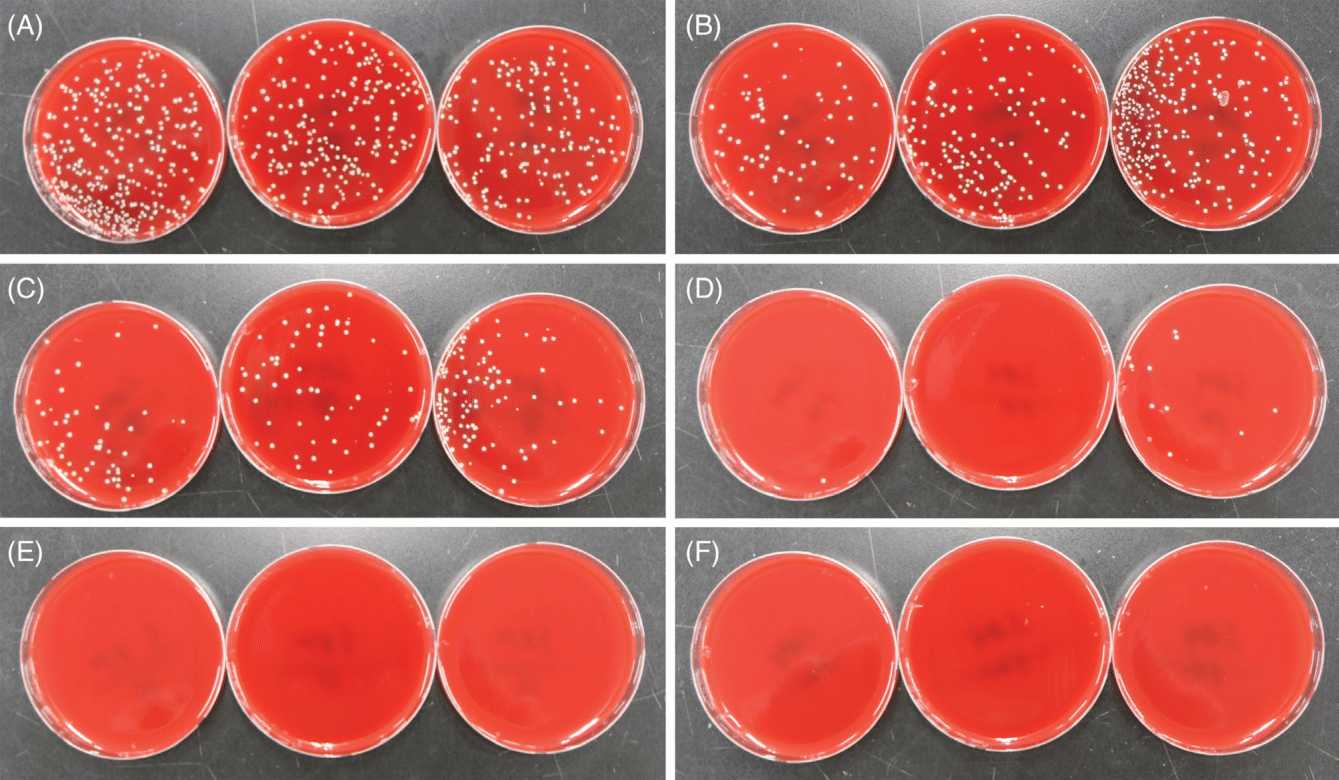

Оставить заявку
Оставить заявку
Мы используем cookie и сервисы веб-аналитики для работы сайта, анализа посещаемости и улучшения сервиса. Продолжая пользоваться сайтом, вы соглашаетесь с использованием cookie. Подробнее в Политике обработки персональных данных.

ОСТАВИТЬ ЗАЯВКУ
Заполняя данную форму, вы соглашаетесь с Правилами обработки персональных данных
Антибактериальное и антикандидное действие импульсов нетермической азотной и аргоновой плазмы атмосферного давления PLADUO
19 Августа 2025
Новые технологии красоты


01
Аннотация
Нетермическая плазма атмосферного давления уничтожает микроорганизмы, непосредственно вступая в реакцию с молекулами углеводородов в клеточной стенке и/или повреждая клеточную мембрану, белки и ДНК заряженными частицами и активными частицами. Целью нашего исследования было оценить антибактериальное и антикандидное воздействие импульсов нетермической азотной и аргоновой плазмы атмосферного давления на различные препараты патогенов. Итоговое антибактериальное и антикандидное воздействие оценивалось путем определения процентного значения сокращения численности патогенных микроорганизмов и уровня контаминации в колониях. Импульсы азотной плазмы, подаваемые при настройке подачи энергии в 1,5 Дж, и импульсы аргоновой плазмы, подаваемые при настройке подачи энергии в 0,5 Дж, продемонстрировали поразительные антибактериальные свойства в отношении Escherichia coli, Klebsiella pneumoniae, Pseudomonas aeruginosa, Staphylococcus aureus, и устойчивого к метициллину Staphylococcus aureus (MRSA) и антикандидные свойства в отношении Candida albicans. Пять импульсов азотной плазмы, выпущенных при настройке подачи энергии в 1,75, 2,5 и 3 Дж, вместо импульсов в 1 Дж, показали существенный антибактериальный эффект в отношении Cutibacterium acnes. В то же время импульсы аргоновой плазмы продемонстрировали антибактериальный эффект в отношении C. acnes при настройках подачи энергии в 0,5 и 0,65 Дж. Импульсы азотной или аргоновой плазмы оказывают антибактериальное и антикандидное действие на бактериальные и грибковые патогены.
02
Введение
Плазменные технологии используются в широком спектре медицинских процедур, где они способствуют заживлению ран, регенерации слоев кожи и оказывают антибактериальное, противогрибковое и противовирусное действие. Исследования показали, что энергия подаваемой плазмы генерирует области термической коагуляции тканей и модификации, характеризующиеся пролиферацией фибробластов, активацией β-катенина и пути ядерного фактора транскрипции κB, а также повышенной регуляцией экспрессии c-Myc и циклина D1. Кроме того, исследования показали, что плазма может уничтожать микроорганизмы, непосредственно вступая в реакцию с молекулами углеводородов в клеточной стенке и/или повреждая клеточную мембрану, бактериальные белки и ДНК.
В медицинских целях плазма может быть получена из источников инертного газа, включая атмосферный воздух, аргон, гелий и азот, и может быть доставлена к ткани-мишени. Для этого используются генераторы сверхвысокой частоты, такие как радиочастотные и микроволновые генераторы, для отделения электронов от атомов и генерации возбужденного ионизированного газа. Спектр эмиссии плазмы зависит от источника газа. Любопытно, что реакции тканей под воздействием плазмы варьируются в зависимости от источника плазмы, настроек подаваемой энергии, длительности импульса, и количества импульсов или времени воздействия. В рамках лабораторного исследования было обнаружено, что аргоновая плазма вызывает микроскопические тканевые реакции в вакуолях в эпидермисе, фолликулярном эпителии и сальных железах кожи живых крыс. Между тем, было продемонстрировано, что азотная плазма вызывает хромофорзависимую термическую коагуляцию тканей и модификацию, глубина и степень которой зависят от энергии, подаваемой на кожу человека и крысы в рамках in vivo исследования.
Было обнаружено, что за счет ускорения реэпителизации, ангиогенеза и формирования стромальной ткани лечение нетермической плазмой атмосферного давления приводит к положительным терапевтическим результатам при лечении острых и хронических ран различного происхождения. Действительно, было доказано, что благодаря действию активных компонентов лечение плазмой оказывает противовоспалительное и антипролиферативное действие при воспалительных заболеваниях кожи, например, при атопическом дерматите и псориазе. Положительный терапевтический эффект лечения плазмой, по-видимому, обусловлен антибактериальным и противогрибковым действием плазмы на колонизированные патогенные или потенциально патогенные микроорганизмы, которые могут вызывать или усугублять острые или хронические раны или различные воспалительные заболевания. В данном пилотном исследовании мы стремились оценить антибактериальное и антикандидное воздействие импульсов микроволновой нетермической азотной или аргоновой плазмы атмосферного давления. Для этого культуры различных патогенов, включая Escherichia coli, Klebsiella pneumoniae, Pseudomonas aeruginosa, Staphylococcus aureus, устойчивый к метициллину Staphylococcus aureus (MRSA), Candida albicans и Cutibacterium acnes, обрабатывались импульсами азотной и аргоновой плазмы при различных параметрах проведения процедуры. Затем итоговое антибактериальное и антикандидное воздействие оценивалось путем определения процентного значения сокращения численности патогенных микроорганизмов в колониях и расчета сокращения контаминации.
В медицинских целях плазма может быть получена из источников инертного газа, включая атмосферный воздух, аргон, гелий и азот, и может быть доставлена к ткани-мишени. Для этого используются генераторы сверхвысокой частоты, такие как радиочастотные и микроволновые генераторы, для отделения электронов от атомов и генерации возбужденного ионизированного газа. Спектр эмиссии плазмы зависит от источника газа. Любопытно, что реакции тканей под воздействием плазмы варьируются в зависимости от источника плазмы, настроек подаваемой энергии, длительности импульса, и количества импульсов или времени воздействия. В рамках лабораторного исследования было обнаружено, что аргоновая плазма вызывает микроскопические тканевые реакции в вакуолях в эпидермисе, фолликулярном эпителии и сальных железах кожи живых крыс. Между тем, было продемонстрировано, что азотная плазма вызывает хромофорзависимую термическую коагуляцию тканей и модификацию, глубина и степень которой зависят от энергии, подаваемой на кожу человека и крысы в рамках in vivo исследования.
Было обнаружено, что за счет ускорения реэпителизации, ангиогенеза и формирования стромальной ткани лечение нетермической плазмой атмосферного давления приводит к положительным терапевтическим результатам при лечении острых и хронических ран различного происхождения. Действительно, было доказано, что благодаря действию активных компонентов лечение плазмой оказывает противовоспалительное и антипролиферативное действие при воспалительных заболеваниях кожи, например, при атопическом дерматите и псориазе. Положительный терапевтический эффект лечения плазмой, по-видимому, обусловлен антибактериальным и противогрибковым действием плазмы на колонизированные патогенные или потенциально патогенные микроорганизмы, которые могут вызывать или усугублять острые или хронические раны или различные воспалительные заболевания. В данном пилотном исследовании мы стремились оценить антибактериальное и антикандидное воздействие импульсов микроволновой нетермической азотной или аргоновой плазмы атмосферного давления. Для этого культуры различных патогенов, включая Escherichia coli, Klebsiella pneumoniae, Pseudomonas aeruginosa, Staphylococcus aureus, устойчивый к метициллину Staphylococcus aureus (MRSA), Candida albicans и Cutibacterium acnes, обрабатывались импульсами азотной и аргоновой плазмы при различных параметрах проведения процедуры. Затем итоговое антибактериальное и антикандидное воздействие оценивалось путем определения процентного значения сокращения численности патогенных микроорганизмов в колониях и расчета сокращения контаминации.
03
Методы
Мы получили образцы E. coli из Американской коллекции типовых культур (ATCC) 25 922, K. pneumoniae ATCC 13 883, P. aeruginosa ATCC 9027, S. aureus ATCC 25 923, метициллинрезистентного золотистого стафилококка (MRSA) (клинический изолят), C. albicans ATCC 14 053, и C. acnes (клинический изолят) из коллекции микроорганизмов клинических лабораторий г. Сеула (Южная Корея, г. Йонъин). Стандартные суспензии E. coli, K. pneumoniae, P. aeruginosa, S. aureus и MRSA были посеяны в дозе 0,1 мл и культивированы на планшетах с кровяным агаром при 35 °C в течение 12 ч. Стандартную суспензию C. albicans объемом 0.1 мл высеяли на планшеты с декстрозным агаром Сабуро («Дифко» (Difco), штат Мичиган, г. Детройт) и инкубировали при 35 °C в течение 48 часов.
Стандартную суспензию C. acnes объемом 0,1 мл высеяли и культивировали на планшете с кровяным агаром в анаэробной камере при 35 °C в течение 72 ч. Затем соответствующие колонии из вышеуказанных микроорганизмов суспендировали в 0,9% стерильном физиологическом растворе с использованием стерильной бактериологической петли, а отдельные изоляты разбавили до получения суспензий мутности 0,5 по Макфарланду. Для дальнейшей оценки антибактериального и антикандидного воздействия импульсов плазмы были проведены дополнительные эксперименты с использованием более высоких концентраций патогенов. Для этих экспериментов были использованы четыре патогена (S. aureus, MRSA, C. albicans, and C. acnes) которые были подготовлены и разбавлены до достижения мутности 3,0 по Макфарланду. Концентрации препаратов приведены в Таблице 1.
Стандартную суспензию C. acnes объемом 0,1 мл высеяли и культивировали на планшете с кровяным агаром в анаэробной камере при 35 °C в течение 72 ч. Затем соответствующие колонии из вышеуказанных микроорганизмов суспендировали в 0,9% стерильном физиологическом растворе с использованием стерильной бактериологической петли, а отдельные изоляты разбавили до получения суспензий мутности 0,5 по Макфарланду. Для дальнейшей оценки антибактериального и антикандидного воздействия импульсов плазмы были проведены дополнительные эксперименты с использованием более высоких концентраций патогенов. Для этих экспериментов были использованы четыре патогена (S. aureus, MRSA, C. albicans, and C. acnes) которые были подготовлены и разбавлены до достижения мутности 3,0 по Макфарланду. Концентрации препаратов приведены в Таблице 1.
Подготовка патогенных микроорганизмов

Таблица 1 Препараты патогенов и количество высаженных патогенов
Обработка патогенных микроорганизмов импульсами азотной и аргоновой плазмы
В этом исследовании для генерации импульсов применялся плазменный генератор (PLADUO™; ООО «Шенб Ко.» («Shenb Co., Ltd»), Южная Корея, г. Сеул), использующий инертный аргон и азот. Культуры различных патогенов были обработаны импульсами азотной или аргоновой плазмы. Для оценки антимикробного действия источников плазмы по 5 мкл каждой из стандартных суспензий E. coli, K. pneumoniae, P. aeruginosa, S. aureus, MRSA, и C. albicans с мутностью 0,5 по Макфарланду были высеены в лунки 24-луночного микротитровального планшета с плоским дном и дегидрированы в боксе биологической безопасности в течение 60 мин. Затем в каждую лунку подали три, шесть, девять и 11 импульсов азотной плазмы последовательно с объемом подачи в 0,51 мл/импульс, настройкой подачи энергии в 1,5 Дж и длительностью импульса 13 мс на расстоянии 5 мм от конца сопла до дна лунки (Рис. 1). Дополнительно, пять, 10, 15, 30, 60 и 90 последовательных импульсов аргоновой плазмы при объеме подачи 0,44 мл/импульс, настройкой подачи энергии в 0,5 Дж, длительности импульса 12 мс и расстоянии 5 мм были поданы в заполненные лунки отдельного планшета. Затем обработанные плазмой патогенные микроорганизмы были собраны стерильным тампоном и полосками нанесены на планшеты с кровяным агаром или декстрозным агаром Сабуро. Обработанные плазмой патогены культивировались в течение 24 ч (E. coli, K. pneumoniae, P. aeruginosa, S. aureus и MRSA), 48 ч (C. albicans) и 72 ч (C. acnes), после чего был произведен подсчет колоний.
Для дополнительных экспериментов по 5 мкл каждой из стандартных суспензий S. aureus, MRSA, C. albicans и C. acnes при мутности 3,0 по Макфарланду были высеены в лунки 24-луночного микротитровального планшета с плоским дном и дегидрированы в боксе биологической безопасности в течение 60 мин.14 Затем пять проходок азотной плазмой со следующими параметрами: подача 0,4 мл/импульс, 1 Дж и 10 мс; 0,63 мл/импульс, 1,75 Дж и 16 мс; 0,87 мл/импульс, 2,5 Дж и 22 мс; и 1,11 мл/импульс, 3 Дж и 28 мс подавали на каждую лунку на расстоянии 5 мм от конца сопла до дна лунки (Рис. 2A). В заполненные лунки отдельного планшета подали пять, 10, 15, 30, 60 и 90 последовательных импульсов аргоновой плазмы со следующими параметрами подачи: 0,44 мл/импульс, 0,5 Дж и 12 мс и 0,59 мл/импульс, 0,65 Дж и 16 мс в каждую лунку на расстоянии 5 мм от конца сопла до дна лунки (Рис. 2B). Также как и ранее, обработанные плазмой патогены были собраны стерильным тампоном и нанесены полосками на планшеты с кровяным агаром или декстрозным агаром Сабуро. После этого обработанные плазмой патогены культивировались в течение 24−72 ч., после чего было подсчитано количество колоний. Кроме того, изменения температуры были зафиксированы с помощью бесконтактного инфракрасного термометра в исходном состоянии, сразу после плазменной обработки и через 5 мин после обработки в 5 мкл каждой из стандартных суспензий патогенов в каждом из экспериментальных условий (Таблица 2). Все эксперименты были проведены трижды в один и тот же день.
Для дополнительных экспериментов по 5 мкл каждой из стандартных суспензий S. aureus, MRSA, C. albicans и C. acnes при мутности 3,0 по Макфарланду были высеены в лунки 24-луночного микротитровального планшета с плоским дном и дегидрированы в боксе биологической безопасности в течение 60 мин.14 Затем пять проходок азотной плазмой со следующими параметрами: подача 0,4 мл/импульс, 1 Дж и 10 мс; 0,63 мл/импульс, 1,75 Дж и 16 мс; 0,87 мл/импульс, 2,5 Дж и 22 мс; и 1,11 мл/импульс, 3 Дж и 28 мс подавали на каждую лунку на расстоянии 5 мм от конца сопла до дна лунки (Рис. 2A). В заполненные лунки отдельного планшета подали пять, 10, 15, 30, 60 и 90 последовательных импульсов аргоновой плазмы со следующими параметрами подачи: 0,44 мл/импульс, 0,5 Дж и 12 мс и 0,59 мл/импульс, 0,65 Дж и 16 мс в каждую лунку на расстоянии 5 мм от конца сопла до дна лунки (Рис. 2B). Также как и ранее, обработанные плазмой патогены были собраны стерильным тампоном и нанесены полосками на планшеты с кровяным агаром или декстрозным агаром Сабуро. После этого обработанные плазмой патогены культивировались в течение 24−72 ч., после чего было подсчитано количество колоний. Кроме того, изменения температуры были зафиксированы с помощью бесконтактного инфракрасного термометра в исходном состоянии, сразу после плазменной обработки и через 5 мин после обработки в 5 мкл каждой из стандартных суспензий патогенов в каждом из экспериментальных условий (Таблица 2). Все эксперименты были проведены трижды в один и тот же день.

Рис. 1 Обработка препаратов микроорганизмов азотной и аргоновой плазмой в микротитровальном планшете с плоским дном. Поликарбонатная рама удерживает манипулу плазменного генератора (отмечен звездочкой) и микротитровальный планшет с плоским дном, в каждой лунке которого посеяны препараты микроорганизмов.
Оценка антибактериального и антикандидного воздействия
Антибактериальное и антикандидное воздействие импульсов азотной и аргоновой плазмы было количественно проанализировано путем расчета уменьшения количества жизнеспособных микроорганизмов. Антимикробная активность плазмы представлена в процентах сокращения численности патогенных микроорганизмов в колониях и сокращении контаминации, как указано ниже:
Процентное сокращение = ((А — B) * 100) / 2
Процентное сокращение = ((А — B) * 100) / 2

Рис. 2 Немедленная реакция на плазменную обработку лунок 24-луночного микротитровального планшета с плоским дном с препаратами микроорганизмов. (А) Импульсы азотной и (Б) аргоновой плазмы подавались на суспензии метициллинрезистентного золотистого стафилококка при мутности 3,0 по Макфарланду. Вид сверху.

Таблица 2 Изменения температуры в 5 мкл каждой из стандартных суспензий патогенов в различных экспериментальных условиях.

Таблица 3 Антибактериальное воздействие импульсов азотной и аргоновой плазмы на Escherichia coli, Klebsiella pneumoniae и Pseudomonas aeruginosa
Сокращение контаминации = log10 (A/B) or log10 (A) — log10 (B)
где A — количество жизнеспособных микроорганизмов до обработки плазмой, а B — количество жизнеспособных микроорганизмов после обработки плазмой.
где A — количество жизнеспособных микроорганизмов до обработки плазмой, а B — количество жизнеспособных микроорганизмов после обработки плазмой.
04
Результаты
Импульсы азотной плазмы с подачей энергии в 1,5 Дж продемонстрировали существенное антибактериальное воздействие на грамотрицательные микроорганизмы, включая E. coli, K. pneumoniae и P. aeruginosa (Таблица 3). Их антибактериальный эффект стал особенно очевиден при выпуске трех импульсов плазмы для лечения E. coli и P. aeruginosa, тогда как для лечения K. pneumoniae, по-видимому, требовалось более трех импульсов азотной плазмы. Между тем, импульсы аргоновой плазмы с подачей энергии в 0,5 Дж также оказали удивительный антибактериальный эффект на E. coli, K. pneumoniae и P. aeruginosa. Любопытно, что для уменьшения колонии P. aeruginosa потребовалось по меньшей мере 10 импульсов аргоновой плазмы, а для K. pneumoniae — 30, 60 и 90 импульсов.
Воздействие импульсов плазмы на грамотрицательные микроорганизмы
Воздействие импульсов плазмы на грамположительные микроорганизмы и Candida
На суспензиях с мутностью 0,5 по Макфарланду импульсы азотной плазмы с подачей энергии в 1,5 Дж показали заметное антибактериальное воздействие на грамположительные микроорганизмы, включая S. aureus и MRSA, и антикандидный эффект на C. albicans (Таблица 4). При этом сокращение колоний S. aureus и C. albicans на >99% было достигнуто при шести, девяти и 11 импульсах азотной плазмы, но не при трех. Между тем, >99%-ное сокращение колоний MRSA было получено при использовании девяти и 11 импульсов, но не при использовании трех или шести. Кроме того, импульсы аргоновой плазмы с подачей энергии в 0,5 Дж показали значительное антибактериальное и антикандидное воздействие на S. aureus, MRSA и C. albicans. Количество импульсов для достижения >99%-ного уменьшения колоний с помощью аргоновой плазмы составило 60 и 90 для лечения S. aureus и 90 — для MRSA. Однако ни одно из экспериментальных условий с аргоновой плазмой не привело к >99%-ному уменьшению колоний C. albicans.
В рамках дополнительного эксперимента с суспензиями при мутности 3,0 по Макфарланду пять импульсов азотной плазмы показали значительный антибактериальный и антикандидный эффект в отношении MRSA и C. albicans (Таблица 5). Было обнаружено уменьшение колоний MRSA на >99% при настройках подачи энергии в 1, 1,75, 2,5 и 3 Дж (Рис. 3), тогда как у C. albicans это было заметно при 2,5 и 3 Дж, но не при 1 или 1,75 Дж. Дальнейшие эксперименты с использованием импульсов аргоновой плазмы при подаче энергии 0,5 и 0,65 Дж выявили антибактериальный и антикандидный эффект в отношении S. aureus, MRSA и C. albicans (Рис. 4). Обработка аргоновой плазмой при 0,65 Дж привела к более высоким значениям процентного сокращения численности микроорганизмов и сокращению контаминации, чем обработка аргоновой плазмой при 0,5 Дж у S. aureus, MRSA и C. albicans. Кроме того, большее количество импульсов аргоновой плазмы привело к более высоким значениям сокращения контаминации у всех микроорганизмов.
В рамках дополнительного эксперимента с суспензиями при мутности 3,0 по Макфарланду пять импульсов азотной плазмы показали значительный антибактериальный и антикандидный эффект в отношении MRSA и C. albicans (Таблица 5). Было обнаружено уменьшение колоний MRSA на >99% при настройках подачи энергии в 1, 1,75, 2,5 и 3 Дж (Рис. 3), тогда как у C. albicans это было заметно при 2,5 и 3 Дж, но не при 1 или 1,75 Дж. Дальнейшие эксперименты с использованием импульсов аргоновой плазмы при подаче энергии 0,5 и 0,65 Дж выявили антибактериальный и антикандидный эффект в отношении S. aureus, MRSA и C. albicans (Рис. 4). Обработка аргоновой плазмой при 0,65 Дж привела к более высоким значениям процентного сокращения численности микроорганизмов и сокращению контаминации, чем обработка аргоновой плазмой при 0,5 Дж у S. aureus, MRSA и C. albicans. Кроме того, большее количество импульсов аргоновой плазмы привело к более высоким значениям сокращения контаминации у всех микроорганизмов.
Воздействие импульсов плазмы на C. acnes
Пять импульсов азотной плазмы имели заметный антибактериальный эффект на C. acnes при настройках подачи энергии в 1,75, 2,5 и 3 Дж (Таблица 6). Обработка азотной плазмой при более высоких настройках подачи энергии привела к более высоким значениям сокращения контаминации. Явного сокращения популяции колонии C. acnes не отмечалось после выпуска пяти импульсов азотной плазмы при настройке подачи энергии в 1 Дж. В то же время эксперименты с импульсами аргоновой плазмы с настройками подачи энергии в 0,5 и 0,65 Дж показали заметный антибактериальный эффект на C. acnes. Что касается настроек подачи аргоновой плазмы, то более высокие настройки подачи энергии или большее количество импульсов плазмы привели к более высоким значениям сокращения контаминации. Таким образом, пять импульсов аргоновой плазмы, направленных на препараты C. acnes, при настройках подачи энергии 0,5 и 0,65 Дж привели к более значительному антибактериальному эффекту по сравнению с пятью импульсами азотной плазмы при 1 Дж.

Таблица 4 Оценка антибактериального и антикандидного воздействия импульсов азотной и аргоновой плазмы на стандартные суспензии Staphylococcus aureus, MRSA и Candida albicans при мутности 0,5 по Макфарланду.

Таблица 5 Антибактериальное и антикандидное воздействие азотной и аргоновой плазмы на суспензии Staphylococcus aureus, MRSA и Candida albicans при мутности 3,0 по Макфарланду.
Рис 3 Культивация обработанного азотной плазмой устойчивого к метициллину Staphylococcus aureus (MRSA). Стандартные суспензии MRSA при мутности 3,0 по Макфарланду, которые высеяли в лунки 24-луночного микротитровального планшета с плоским дном и дегидрировали, были обработаны пятью проходками азотной плазмы подряд при (A) 1 Дж, (B) 1,75 Дж, (C) 2,5 Дж и (D) 3 Дж. Затем обработанные плазмой изоляты MRSA собирали стерильным тампоном и наносили полосками на кровяной агар.
05
Заключение
В настоящем исследовании мы задокументировали антибактериальное и антикандидное воздействие импульсов микроволновой нетермической азотной и аргоновой плазмы атмосферного давления на различные патогены. В нашем исследовании оценивалась эффективность плазмы против штаммов грамотрицательных бактерий, включая E. coli, K. pneumoniae, P. aeruginosa; штаммов грамположительных бактерий, включая S. aureus, MRSA и C. acnes; и одного штамма грибов C. albicans, каждый из которых демонстрирует структурные различия: для сравнения, грамотрицательные бактерии обладают слоистыми клеточными оболочками, которые состоят из внешней мембраны, тонкой клеточной стенки (пептидогликан) и внутренней цитоплазматической мембраны. Грамположительные бактерии имеют толстые клеточные стенки, состоящие из нескольких слоев пептидогликана без внешней мембраны.
Рис. 4 Культивация Staphylococcus aureus, обработанного аргоновой плазмой. Стандартные суспензии S. aureus при мутности 3,0 по Макфарланду, которые высеяли в лунки 24-луночного микротитровального планшетаа и дегидрировали, обрабатывали (A) 5, (B) 10, (C) 15, (D) 30, (E) 60 и (F) 90 последовательными проходками аргоновой плазмы при настройках подачи энергии в 0,65 Дж. Затем обработанные плазмой изоляты S. aureus были собраны стерильным тампоном и нанесены полосками на кровяной агар.

Таблица 6 Антибактериальное воздействие импульсов азотной и аргоновой плазмы на Cutibacterium acnes
Грибы имеют очень толстые клеточные стенки, состоящие из жестких слоев полисахаридов. Ранее мы оценивали воздействие азотной и аргоновой плазмы на кожу и кожные придатки на живой животной модели с использованием того же генератора плазмы (PLADUO™), что и в настоящем исследовании. В нем пять последовательных проходок азотной плазмой при настройках подачи энергии в 1,0, 1,5, 2,0, 2,5 и 3,0 Дж вызывали заметную коагуляцию тканей на глубине 31.5 ± 8.3, 94.9 ± 16.9, 171.6, ± 19.7, 381.7 ± 33.6, и 453,3 ± 75,7 часов вечера, соответственно, в День 0.
Обработка азотной плазмой при низких настройках подачи энергии в 1,0, 1,5 и 2,0 Дж привела к увеличению количества фибробластов и коллагеновых волокон в верхних слоях дермы без образования заметных рубцов на 21 день. Между тем, обработка азотной плазмой при высоких настройках подачи энергии в 2,5 и 3,0 Дж вызвала заметное увеличение количества фибробластов и коллагеновых волокон, но также привела к чрезмерному образованию рубцов без заметных пилосебацейных структур на 21-й день.
В этом исследовании импульсы азотной плазмы, подаваемые при настройке подачи энергии в 1,5 Дж, эффективно подавляли пролиферацию E. coli и P. aeruginosa после трех последовательных проходок и K. pneumoniae после шести проходок. Более того, антибактериальный эффект обработки азотной плазмой при 1,5 Дж стал очевиден в отношении S. aureus после трех последовательных проходок и в отношении MRSA — после шести, а антикандидный эффект в отношении C. albicans стал заметен после шести проходок при 1,5 Дж. Дополнительные эксперименты с использованием стандартных суспензий с мутностью 3,0 по Макфарланду показали, что колонизация MRSA может быть заметно ингибирована после пяти проходок азотной плазмой при 1 Дж. Однако только высокоэнергетическая обработка азотной плазмой может иметь антикандидное воздействие против C. albicans. В нашем предыдущем in vivo исследовании на крысах мы рекомендовали низкоэнергетические настройки (<2,0 Дж) и/или ограниченное количество проходок (<6) азотной плазмой для индуцирования антибактериального эффекта, чтобы избежать образования серьезных рубцов на коже человека в рамках исследований in vivo. Соответственно, еще предстоит оценить параметры лечения азотной плазмой, включая подачу энергии и количество импульсов, для лечения C. albicans и предотвращения побочных эффектов на коже человека.
Наша исследовательская группа ранее оценила кожу крыс в рамках in vivo исследования после обработки пятью последовательными импульсами нетермической аргоновой плазмы атмосферного давления с настройкой подачи энергии в диапазоне от 0,35 до 0,85 Дж. В нем образцы, полученные после обработки, демонстрировали немедленные кожные реакции, включая истончение эпидермиса, инфильтрацию воспалительных клеток в папиллярной дерме и термические реакции тканей в себоцитах. Обработка аргоновой плазмой с 15 выполненными проходками с настройками подачи энергии в 0,8 и 1,3 Дж вызвала выраженные реакции в вакуолях тканей по всему эпидермису с инфильтрацией воспалительных клеток в верхних слоях дермы в коже крыс в нулевой день в рамках in vivo исследования. Хотя у большинства образцов кожи крыс, обработанных аргоновой плазмой, наблюдалась полная реэпителизация с неоколлагенезом в верхних слоях дермы без образования заметных рубцов на 10-й или 21-й день, образцы, обработанные 15 проходками аргоновой плазмы при 1,3 Дж, показали неполную эпителизацию и разрушение пилосебайцейных комплексов с сильной инфильтрацией в верхних и средних слоях дермы на 10 день. В настоящем in vitro исследовании использовались настройки подачи энергии в 0,5 и 0,65 Дж, и оценивалось воздействие различного количества импульсов аргоновой плазмы (10, 15, 30, 60 и 90 проходок) на микроорганизмы.
В рамках данного исследования 10 и более импульсов аргоновой плазмы эффективно подавляли E. coli и P. aeruginosa при 0,5 Дж, тогда как для K. pneumoniae требовалось 30 или более импульсов. Антибактериальный эффект импульсов аргоновой плазмы стал очевиден при 0,5 Дж на 24-луночных микротитровальных планшетах после пяти импульсов для лечения S. aureus, 10 — для MRSA и 60 — для C. albicans. Интересно, что дополнительные эксперименты с суспензиями при мутности 3,0 по Макфарланду, которые содержали более высокие концентрации патогенов, по сравнению с суспензиями при мутности 0,5 по Макфарланду, показали, что для достижения антибактериального и антикандидного эффекта на S. aureus, MRSA и C. albicans требовалось меньшее количество импульсов аргоновой плазмы. Кроме того, импульсы аргоновой плазмы при 0,65 Дж были более эффективны при обработке этих препаратов микроорганизмов, чем импульсы при 0,5 Дж.
Пролиферация C. acnes является одним из основных патогенных факторов, влияющих на развитие обыкновенных угрей. Здесь пять последовательных импульсов азотной плазмы эффективно ингибировали колонизацию C. acnes при настройке подачи энергии в 1,75 Дж или выше. Эффективность обработки напрямую зависит от настройки подачи энергии. Более того, все экспериментальные условия с использованием импульсов аргоновой плазмы при 0,5 и 0,65 Дж продемонстрировали антибактериальное действие на C. acnes. Наше предыдущее исследование продемонстрировало, что многократные импульсы аргоновой плазмы приводят к термическим тканевым реакциям в себоцитах и заметным микроскопическим изменениям вакуолей в кератиноцитах эпидермиса и фолликулярном эпителии. Соответственно, мы предположили, что лечение импульсами плазмы может быть использовано в качестве дополнительного или альтернативного метода лечения обычных угрей. Тем не менее, поскольку C. acnes является аэротолерантной, анаэробной грамположительной бактерией, наше пилотное исследование не полностью отражает антибактериальное воздействие импульсов азотной и аргоновой плазмы на C. acnes.
В заключение можно отметить, что мы обнаружили, что импульсы азотной и аргоновой плазмы обладают антибактериальным и антикандидным воздействием на различные микроорганизмы, включая E. coli, K. pneumoniae, P. aeruginosa, S. aureus, MRSA, C. albicans и C. acnes. Соответственно, мы предполагаем, что импульсы азотной или аргоновой плазмы можно использовать для лечения различных инфекционных состояний как дополнение или альтернативу системным и местным антибактериальным или антикандидным методам лечения. Тем не менее, ограничения нашего исследования заключаются в отсутствии контролируемых экспериментов с равной площадью поверхностей между плазмой и каждой лункой, а также отсутствии оценки токсичности источников инертных газов в лабораторном исследовании. Соответственно, необходимы дальнейшие исследования, чтобы лучше описать реакции на газообразные источники плазмы, а также оптимальные настройки подачи энергии и количество плазменных импульсов для отдельных микроорганизмов.
Обработка азотной плазмой при низких настройках подачи энергии в 1,0, 1,5 и 2,0 Дж привела к увеличению количества фибробластов и коллагеновых волокон в верхних слоях дермы без образования заметных рубцов на 21 день. Между тем, обработка азотной плазмой при высоких настройках подачи энергии в 2,5 и 3,0 Дж вызвала заметное увеличение количества фибробластов и коллагеновых волокон, но также привела к чрезмерному образованию рубцов без заметных пилосебацейных структур на 21-й день.
В этом исследовании импульсы азотной плазмы, подаваемые при настройке подачи энергии в 1,5 Дж, эффективно подавляли пролиферацию E. coli и P. aeruginosa после трех последовательных проходок и K. pneumoniae после шести проходок. Более того, антибактериальный эффект обработки азотной плазмой при 1,5 Дж стал очевиден в отношении S. aureus после трех последовательных проходок и в отношении MRSA — после шести, а антикандидный эффект в отношении C. albicans стал заметен после шести проходок при 1,5 Дж. Дополнительные эксперименты с использованием стандартных суспензий с мутностью 3,0 по Макфарланду показали, что колонизация MRSA может быть заметно ингибирована после пяти проходок азотной плазмой при 1 Дж. Однако только высокоэнергетическая обработка азотной плазмой может иметь антикандидное воздействие против C. albicans. В нашем предыдущем in vivo исследовании на крысах мы рекомендовали низкоэнергетические настройки (<2,0 Дж) и/или ограниченное количество проходок (<6) азотной плазмой для индуцирования антибактериального эффекта, чтобы избежать образования серьезных рубцов на коже человека в рамках исследований in vivo. Соответственно, еще предстоит оценить параметры лечения азотной плазмой, включая подачу энергии и количество импульсов, для лечения C. albicans и предотвращения побочных эффектов на коже человека.
Наша исследовательская группа ранее оценила кожу крыс в рамках in vivo исследования после обработки пятью последовательными импульсами нетермической аргоновой плазмы атмосферного давления с настройкой подачи энергии в диапазоне от 0,35 до 0,85 Дж. В нем образцы, полученные после обработки, демонстрировали немедленные кожные реакции, включая истончение эпидермиса, инфильтрацию воспалительных клеток в папиллярной дерме и термические реакции тканей в себоцитах. Обработка аргоновой плазмой с 15 выполненными проходками с настройками подачи энергии в 0,8 и 1,3 Дж вызвала выраженные реакции в вакуолях тканей по всему эпидермису с инфильтрацией воспалительных клеток в верхних слоях дермы в коже крыс в нулевой день в рамках in vivo исследования. Хотя у большинства образцов кожи крыс, обработанных аргоновой плазмой, наблюдалась полная реэпителизация с неоколлагенезом в верхних слоях дермы без образования заметных рубцов на 10-й или 21-й день, образцы, обработанные 15 проходками аргоновой плазмы при 1,3 Дж, показали неполную эпителизацию и разрушение пилосебайцейных комплексов с сильной инфильтрацией в верхних и средних слоях дермы на 10 день. В настоящем in vitro исследовании использовались настройки подачи энергии в 0,5 и 0,65 Дж, и оценивалось воздействие различного количества импульсов аргоновой плазмы (10, 15, 30, 60 и 90 проходок) на микроорганизмы.
В рамках данного исследования 10 и более импульсов аргоновой плазмы эффективно подавляли E. coli и P. aeruginosa при 0,5 Дж, тогда как для K. pneumoniae требовалось 30 или более импульсов. Антибактериальный эффект импульсов аргоновой плазмы стал очевиден при 0,5 Дж на 24-луночных микротитровальных планшетах после пяти импульсов для лечения S. aureus, 10 — для MRSA и 60 — для C. albicans. Интересно, что дополнительные эксперименты с суспензиями при мутности 3,0 по Макфарланду, которые содержали более высокие концентрации патогенов, по сравнению с суспензиями при мутности 0,5 по Макфарланду, показали, что для достижения антибактериального и антикандидного эффекта на S. aureus, MRSA и C. albicans требовалось меньшее количество импульсов аргоновой плазмы. Кроме того, импульсы аргоновой плазмы при 0,65 Дж были более эффективны при обработке этих препаратов микроорганизмов, чем импульсы при 0,5 Дж.
Пролиферация C. acnes является одним из основных патогенных факторов, влияющих на развитие обыкновенных угрей. Здесь пять последовательных импульсов азотной плазмы эффективно ингибировали колонизацию C. acnes при настройке подачи энергии в 1,75 Дж или выше. Эффективность обработки напрямую зависит от настройки подачи энергии. Более того, все экспериментальные условия с использованием импульсов аргоновой плазмы при 0,5 и 0,65 Дж продемонстрировали антибактериальное действие на C. acnes. Наше предыдущее исследование продемонстрировало, что многократные импульсы аргоновой плазмы приводят к термическим тканевым реакциям в себоцитах и заметным микроскопическим изменениям вакуолей в кератиноцитах эпидермиса и фолликулярном эпителии. Соответственно, мы предположили, что лечение импульсами плазмы может быть использовано в качестве дополнительного или альтернативного метода лечения обычных угрей. Тем не менее, поскольку C. acnes является аэротолерантной, анаэробной грамположительной бактерией, наше пилотное исследование не полностью отражает антибактериальное воздействие импульсов азотной и аргоновой плазмы на C. acnes.
В заключение можно отметить, что мы обнаружили, что импульсы азотной и аргоновой плазмы обладают антибактериальным и антикандидным воздействием на различные микроорганизмы, включая E. coli, K. pneumoniae, P. aeruginosa, S. aureus, MRSA, C. albicans и C. acnes. Соответственно, мы предполагаем, что импульсы азотной или аргоновой плазмы можно использовать для лечения различных инфекционных состояний как дополнение или альтернативу системным и местным антибактериальным или антикандидным методам лечения. Тем не менее, ограничения нашего исследования заключаются в отсутствии контролируемых экспериментов с равной площадью поверхностей между плазмой и каждой лункой, а также отсутствии оценки токсичности источников инертных газов в лабораторном исследовании. Соответственно, необходимы дальнейшие исследования, чтобы лучше описать реакции на газообразные источники плазмы, а также оптимальные настройки подачи энергии и количество плазменных импульсов для отдельных микроорганизмов.
06
Список литературы
Кубинова С., Зависькова К., Угеркова Л. и др. Нетермическая плазма из атмосферного воздуха способствует заживлению острых поражений кожи у крыс. Scientific Reports («Научные статьи»). 2017;7: с. 5183.
Хайнлин Дж., Циммерман Дж. Л., Земан Ф. и др. Рандомизированное плацебо-контролируемое пилотное исследование холодной атмосферной аргоновой плазмы на донорских участках кожных трансплантатов. Wound Repair Regen («Заживление и регенерация ран»). 2013;21: с. 800−807.
Хайнлин Дж., Исбари Г., Штольц У. и др. Рандомизированное двустороннее плацебо-контролируемое исследование эффективности и безопасности атмосферной нетермической аргоновой плазмы при зуде. J Eur Acad Dermatol Venereol («Журнал Европейской академии дерматологии и венерологии»). 2013;27: с. 324−331.
Виганд С, Байер О, Хорн К и др. Антимикробное воздействие холодной плазмы атмосферного давления на критически важные для медицины культуры дрожжей и бактерий. Skin Pharmacol Physiol («Фармакология и физиология кожи»). 2014;27: с. 25−35.
Вейандт Г. Х., Бенуа С., Беккер Дж.К., Брокер Э. Б., Хэмм Х. Контролируемое послойное удаление аногенитальных бородавок методом коагуляции с использованием аргоновой плазмы. J Dtsch Dermatol Ges («Журнал Немецкого дерматологического общества»). 2005;3: с. 271−275.
Лю Дж.Р., Сюй Г. М., Ши Х. М., Чжан Г. Дж. Низкотемпературная плазма способствует пролиферации фибробластов, активируя путь NF-KB и увеличивая уровень циклина D1. Scientific Reports («Научные статьи»). 2017;7: с. 698.
Ченг К.И., Лин Ж., Ченг Ю. П. и др. Заживление ран у крыс с диабетом, индуцированное стрептозотоцином, с использованием струи аргоновой плазмы атмосферного давления. Scientific Reports («Научные статьи»). 2018;8: с. 214.
Килмер С., Семчишин Н., Шах Г., Фитцпатрик Р. Пилотное исследование по использованию устройства для плазменной регенерации кожи (portrait PSR3) в процедурах полного омоложения лица. Lasers Med Sci («Лазеры в медицине»). 2017;22:101−109.
Элси М.Л., Каммер Дж. Н. Оценка технологии плазменной регенерации кожи для ремоделирования кожи. J Cosmet Dermatol («Журнал косметической дерматологии»). 2008;7: с. 309−311.
Фитцпатрик Р., Бернштейн Э., Айер С., Браун Д., Эндрюс П., Пенни К. Гистопатологическая оценка плазменной системы регенерации кожи (PSR) в сравнении со стандартным карбонным лазером для шлифовки кожи на животноймодели. Lasers Surg Med («Лазеры в хирургии и медицине»). 2008;40: с. 93−99.
Ким Х., Ким Х.Дж., Ким Х. К., Хонг Джи, Чо Сб. Воздействие импульсов аргоновой и азотной плазмы на кожу и кожные придатки на живой модели. Skin Res Technol («Исследования и технологии в области кожи»). 2020;26: с. 81−90.
Чатраи М, Торкаман Г, Хани М, Салехи Х, Шокри Б. Исследование неинвазивных эффектов нетермической плазмы при лечении пролежней на живых моделях. Scientific Reports («Научные статьи»). 2018;8: с. 5621.
Ган Л., Чжан С., Пур И. и др. Медицинское применение нетермической плазмы атмосферного давления в дерматологии. J Dtsch Dermatol Ges («Журнал Немецкого дерматологического общества»). 2018;16: с. 7−13.
Шедлер К., Ассадиан О., Браутфергер У. и др. Предлагаемый этап 2/шаг 2 испытания на основе EN 14 561 для стандартизированного тестирования антисептиков ПВП-йода, хлоргексидина диглюконата, полигексанида и октенидина дигидрохлорида для обработки ран на живых моделях. BMC Infect Dis («Биомедицинский центральный журнал: Инфекционные заболевания»). 2017; 17:143.
Балданов В.Б., Ранжуров Т. В., Семенов А. П., Гомбоева С. В. Источник струи холодной аргоновой плазмы атмосферного давления и его применение для инактивации бактерий. J TheorAppl Phys («Журнал теоретической и прикладной физики»). 2019;13: с. 95−99.
Голлник Х., Канлифф У., Берсон Д. и др. Лечение акне: отчет глобального альянса по улучшению результатов лечения акне. J Am Acad Dermatol («Журнал Американской академии дерматологии»). 2003;49: с. 1−37.
АВТОРЫ
Чан Ки Ким — Научно-исследовательский институт бактериальной резистентности, Медицинский колледж
Университета Ёнсе, Южная Корея, г. Сеул; Клинические лаборатории г. Сеула, Южная Корея, г. Йонъин
Хису Ким — Новая клиника дерматологии и лазерной терапии «Ёнсе», Южная Корея, г. Инчхон
Хен-Чжо Ким — Клиника дерматологии CNP, Южная Корея, г. Чхонан
Сон Бин Чо — Клиника дерматологии и лазерной терапии «Ёнсе Серан», Южная Корея, г. Сеул
Хайнлин Дж., Циммерман Дж. Л., Земан Ф. и др. Рандомизированное плацебо-контролируемое пилотное исследование холодной атмосферной аргоновой плазмы на донорских участках кожных трансплантатов. Wound Repair Regen («Заживление и регенерация ран»). 2013;21: с. 800−807.
Хайнлин Дж., Исбари Г., Штольц У. и др. Рандомизированное двустороннее плацебо-контролируемое исследование эффективности и безопасности атмосферной нетермической аргоновой плазмы при зуде. J Eur Acad Dermatol Venereol («Журнал Европейской академии дерматологии и венерологии»). 2013;27: с. 324−331.
Виганд С, Байер О, Хорн К и др. Антимикробное воздействие холодной плазмы атмосферного давления на критически важные для медицины культуры дрожжей и бактерий. Skin Pharmacol Physiol («Фармакология и физиология кожи»). 2014;27: с. 25−35.
Вейандт Г. Х., Бенуа С., Беккер Дж.К., Брокер Э. Б., Хэмм Х. Контролируемое послойное удаление аногенитальных бородавок методом коагуляции с использованием аргоновой плазмы. J Dtsch Dermatol Ges («Журнал Немецкого дерматологического общества»). 2005;3: с. 271−275.
Лю Дж.Р., Сюй Г. М., Ши Х. М., Чжан Г. Дж. Низкотемпературная плазма способствует пролиферации фибробластов, активируя путь NF-KB и увеличивая уровень циклина D1. Scientific Reports («Научные статьи»). 2017;7: с. 698.
Ченг К.И., Лин Ж., Ченг Ю. П. и др. Заживление ран у крыс с диабетом, индуцированное стрептозотоцином, с использованием струи аргоновой плазмы атмосферного давления. Scientific Reports («Научные статьи»). 2018;8: с. 214.
Килмер С., Семчишин Н., Шах Г., Фитцпатрик Р. Пилотное исследование по использованию устройства для плазменной регенерации кожи (portrait PSR3) в процедурах полного омоложения лица. Lasers Med Sci («Лазеры в медицине»). 2017;22:101−109.
Элси М.Л., Каммер Дж. Н. Оценка технологии плазменной регенерации кожи для ремоделирования кожи. J Cosmet Dermatol («Журнал косметической дерматологии»). 2008;7: с. 309−311.
Фитцпатрик Р., Бернштейн Э., Айер С., Браун Д., Эндрюс П., Пенни К. Гистопатологическая оценка плазменной системы регенерации кожи (PSR) в сравнении со стандартным карбонным лазером для шлифовки кожи на животноймодели. Lasers Surg Med («Лазеры в хирургии и медицине»). 2008;40: с. 93−99.
Ким Х., Ким Х.Дж., Ким Х. К., Хонг Джи, Чо Сб. Воздействие импульсов аргоновой и азотной плазмы на кожу и кожные придатки на живой модели. Skin Res Technol («Исследования и технологии в области кожи»). 2020;26: с. 81−90.
Чатраи М, Торкаман Г, Хани М, Салехи Х, Шокри Б. Исследование неинвазивных эффектов нетермической плазмы при лечении пролежней на живых моделях. Scientific Reports («Научные статьи»). 2018;8: с. 5621.
Ган Л., Чжан С., Пур И. и др. Медицинское применение нетермической плазмы атмосферного давления в дерматологии. J Dtsch Dermatol Ges («Журнал Немецкого дерматологического общества»). 2018;16: с. 7−13.
Шедлер К., Ассадиан О., Браутфергер У. и др. Предлагаемый этап 2/шаг 2 испытания на основе EN 14 561 для стандартизированного тестирования антисептиков ПВП-йода, хлоргексидина диглюконата, полигексанида и октенидина дигидрохлорида для обработки ран на живых моделях. BMC Infect Dis («Биомедицинский центральный журнал: Инфекционные заболевания»). 2017; 17:143.
Балданов В.Б., Ранжуров Т. В., Семенов А. П., Гомбоева С. В. Источник струи холодной аргоновой плазмы атмосферного давления и его применение для инактивации бактерий. J TheorAppl Phys («Журнал теоретической и прикладной физики»). 2019;13: с. 95−99.
Голлник Х., Канлифф У., Берсон Д. и др. Лечение акне: отчет глобального альянса по улучшению результатов лечения акне. J Am Acad Dermatol («Журнал Американской академии дерматологии»). 2003;49: с. 1−37.
АВТОРЫ
Чан Ки Ким — Научно-исследовательский институт бактериальной резистентности, Медицинский колледж
Университета Ёнсе, Южная Корея, г. Сеул; Клинические лаборатории г. Сеула, Южная Корея, г. Йонъин
Хису Ким — Новая клиника дерматологии и лазерной терапии «Ёнсе», Южная Корея, г. Инчхон
Хен-Чжо Ким — Клиника дерматологии CNP, Южная Корея, г. Чхонан
Сон Бин Чо — Клиника дерматологии и лазерной терапии «Ёнсе Серан», Южная Корея, г. Сеул
Читайте статьи:
30 Июня 2024
Новые технологии красоты


30 Июня 2024
Новые технологии красоты


30 Июня 2024
Новые технологии красоты


Все статьи из блога
Все статьи из блога









